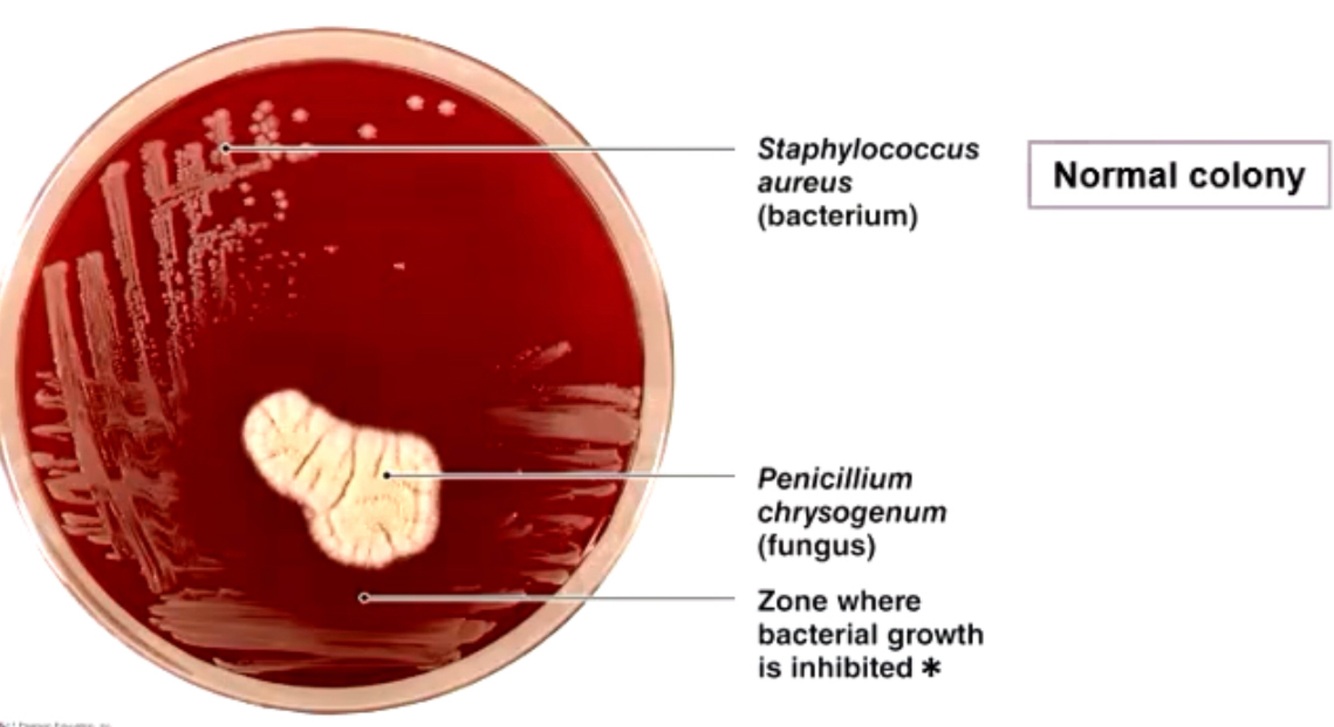

1
Q
Selective toxicity - Paul enrich

A
- early treatments for infectious diseases (such as syphillis) involved the use of highly toxic ‘medicines’ more harmful then the actual disease
- pull ehrlich, notes that some dyes (such as methylene blue) stained microbes better then host cells
- he came up with the idea of a chemical ‘ magic bullet’ to kill microbes but not the host cells
- 1909 the first elective antibiotic Salvarsan or compound 606
2
Q
Selective toxicity is..
A
Something that can kill microbes but not the host
3
Q
Penicillin - Alexandra Fleming
A
In 1982 Alexander Fleming observed that colonies of the bacterium staphyloccoccus bacteria could be destroyed by the mold penicilium notatum
4
Q
How does penicillin work (def in exam)
A
- inferring with the normal formation of the bacterial cell wall by inhibiting the formation of peptidoglycan cross-li is

5
Q
Penicillin shit
A
Different antibiotics are used for different bacteria
Antibiotic for every different part of the bacteria
Mainly

6
Q
How bacteria become resistant to the penicillin
A
- mutation that allowed resistance to penicillin

7
Q
Beta lactamase
A
- enzyme procured by bacteria and used to destroy penicillin ring
- mutation ususally found on a plasmid encode for beta lactamase
- beta lactamase is responsible for breaking the benzene ring on penicillin

8
Q
How many reisitant factors on one plasmid
A
Many
9
Q
Ajt9robic resistance - vertical and horizontal
A
- hroicaontla transfer can also happen across species

10
Q
How to reduce antibiotic resistance
A



